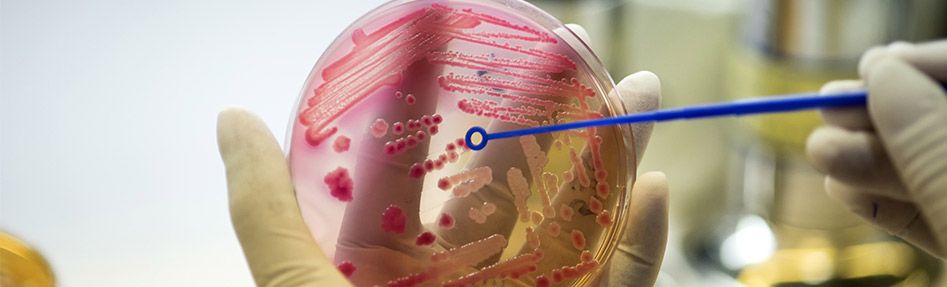

Preliminary announcement: a French-German call for projects on antimicrobial resistance
Antimicrobial resistance affects not only humans, but is tightly connected to animal health and the environment. Thus, France and Germany have both agreed to accelerate efforts based on a “One-Health” approach to combat AMR. This call will enable French and German scientists to build effective collaborations on a common research project involving human and veterinary medicine, as well as other areas of expertise like biology, chemistry, agricultural sciences, environmental research, food technology and social sciences.
Aims of the call
A Franco-German expert committee identified the following two priority topics:
1. Innovative research on AMR in environmental reservoirs (water, soil, wild animals, plants, biofilms on plastic waste, etc.)
- a) Biologic and epidemiologic relevance (risk assessment) of environmental reservoirs for humans or animals regarding the emergence, transmission and dissemination of AMR
- b) Impact of antibiotics, antibiotic residues and other pollutants related to hygienic measures in human and animal health on AMR
- c) Improved or novel methods to quantify and characterize antibiotic-resistant bacteria, genes and mobile genetic elements, antibiotics and antibiotic residues in environ¬mental sample matrices (e.g. wastewater, soil, air)
- d) Innovative interventions to reduce AMR in environmental reservoirs
2. Innovative research on antibiotic resistant bacteria colonizing humans, farm animals, pets and food products
- a) Epidemiology, biology and impact of colonizing antibiotic resistant bacteria
- b) Innovative approaches for prevention or reduction of colonization with antibiotic resistant bacteria
- c) Impact of disinfectants on the emergence of colonizing antibiotic resistant bacteria
Consortium composition
Only bilateral consortia will be funded. The following conditions apply to the composition of consortia:
- There must be one French coordinator and one German coordinator; both must be eligible to receive funding from the respective funding agency, ANR or BMBF
- Additional partners, eligible to receive funding from either agency, can join the consortium
Estimated schedule
There will be a one-stage submission procedure. Proposals must be written in English and must be submitted to VDI/VDE Innovation + Technik GmbH by one of the two coordinators through an electronic submission system available on the VDI/VDE website. No other means of submission will be accepted.
The call is scheduled to open in the third week of December 2019.
The content of the call described in this is pre-announcement is indicative, may be subjected to changes and is not legally binding to the respective ministries or funding agencies.


